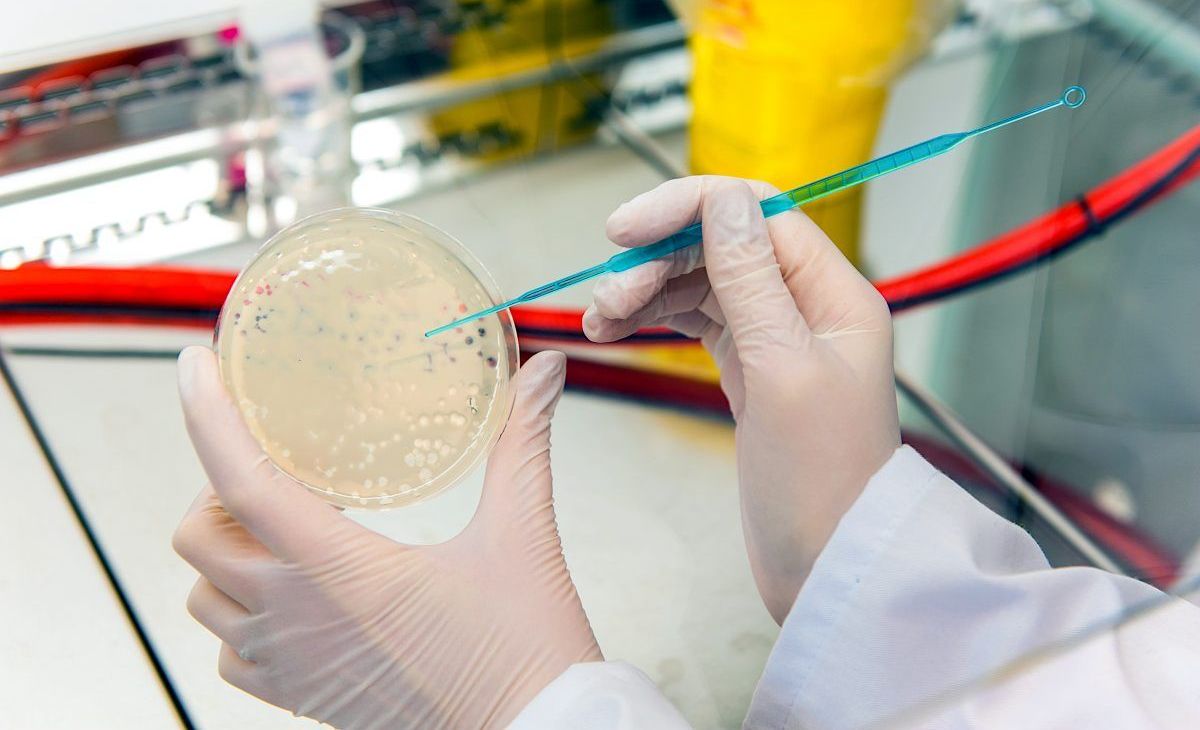

Qué papel cumple la fagoterapia ante la resistencia a los antibióticos
Los fagos son virus que pueden destruir las bacterias nocivas para nosotros
Crédito: Shutterstock
La fagoterapia es un procedimiento médico que puede tener implicaciones muy importantes en nuestra relación con las bacterias. A continuación ahondamos un poco más en esta terapia médica y su incidencia en nuestra salud.
¿Qué es la fagoterapia?
Según los médicos Jordi y Nuria Reina en su artículo para la NCBI, la fagoterapia es una alternativa de tratamiento que consiste en el uso de fagos para resolver el inconveniente de la resistencia bacteriana que algunas bacterias han desarrollado contra los fármacos que deberían eliminarlas.
Los fagos son virus que infectan bacterias al inyectar su material genético en ellas. El fago se expande dentro de la bacteria, haciéndola explotar en último término, permitiendo así la expansión de los fagos para que infecten más bacterias.
Dado que los fagos pueden destruir bacterias, se ha propuesto su uso para destruir bacterias peligrosas para el cuerpo humano porque, a pesar de que los fagos no pueden destruir todas las especies posibles de bacterias, sí pueden erradicar las que se han hecho resistentes a los antibióticos.
Problemas en torno a la fagoterapia
Por prometedora que sea la fagoterapia, hay algunos inconvenientes que aún le impiden ser un tratamiento comercial y de uso masivo en la medicina.
La industria farmacéutica no ha hecho un mayor esfuerzo para preparar a los fagos para el uso humano mediante tratamiento médicos, por lo que esta terapia no se encuentra del todo desarrollada y no se conocen todas las implicaciones que puede tener en nosotros.
Por otro lado, las autoridades sanitarias mundiales no han regularizado el uso médico de los fagos porque no se esperaba que pudieran ser empleados para el beneficio de los pacientes, por lo que no existen guías de producción, calidad ni de seguridad.
Todavía se requieren muchos estudios para determinar la viabilidad de la fagoterapia como un procedimiento terapéutico completamente controlable y seguro para la salud del paciente, por lo que aún no puede ser empleado a gran escala.





